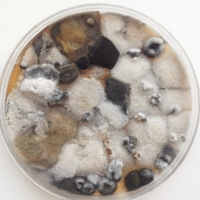
Hidden Household Mold Can Cause Serious Health Hazards Hidden Household Mold Can Cause Serious Health Hazards

Tag: respiratory health
The Underrated Health Benefits of Fresh Oregano
You probably know oregano as the go-to herb for pizza and pasta, but this little leafy powerhouse is so much more than a kitchen...
5 Best Foods And Teas For Healthy Lungs
“Breath is the finest gift of nature. Be grateful for this wonderful gift,” says Amit Ray, the Indian author who has spent a lifetime...
Ladies: Be Careful Of Breathing In This Household Cleaner
Whether you love housework or hate it, there’s something you need to know: Housework may be bad for your health. But it’s not the...
Suffer From Asthma? Ditch Your Steroid Inhaler And Try This Trick...
Millions of people in the United States, and across the world, have asthma. This condition, defined broadly as inflammation of the airways, can greatly...
Is Your Fireplace Giving You Lung Cancer?
There is nothing more soothing or romantic than the soft glow, rich aroma and pop and crackle of a real wood fire. I have...
Hidden Household Mold Can Cause Serious Health Hazards
This picture comes from a person’s house in Salem where I have my practice. She received a mold-growing kit from us. They are very...
Does Asthma Only Develop in Young People?
Q. I'm 50 years old, and lately I've been wheezing when I play tennis. Can I get asthma at my age?
A. You can get...
Rise in Whooping Cough Linked to Gut Health and Obesity in...
Around the world, whooping cough is being seen at the highest rates in 50 years. In a recent study from Australia, researchers are finding...